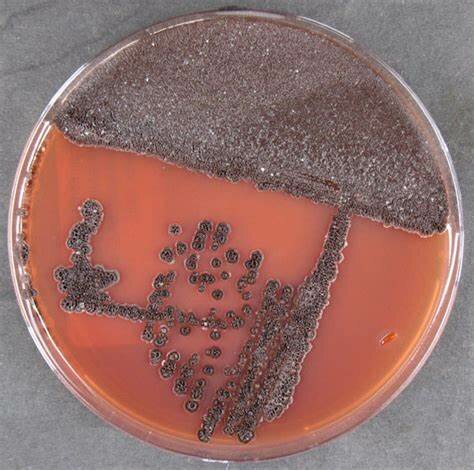
Saccharopolyspora erythraea

-
 En el año 2000 a.C Moisés ducto leyes sobre cuales alimentos se podían comer y cuales se debían desechar.
En el año 2000 a.C Moisés ducto leyes sobre cuales alimentos se podían comer y cuales se debían desechar. -
En el año 1500 a.C en Egipto, el papiro de Ebers hace referencia a venenos conocidos.
-
 En el año 300 a.C en Roma se registraron relatos de intoxicaciones alimentarias atribuidas a productos químicos, debido a que en esta época el plomo era usado para la elaboración de utensilios de cocina y acueductos, contaminando el agua y los alimentos
En el año 300 a.C en Roma se registraron relatos de intoxicaciones alimentarias atribuidas a productos químicos, debido a que en esta época el plomo era usado para la elaboración de utensilios de cocina y acueductos, contaminando el agua y los alimentos -
 En el año 1674 Antony van Leeuwenhoek observo las bacterias por primera vez a través de lentes que formaban un microscopio
En el año 1674 Antony van Leeuwenhoek observo las bacterias por primera vez a través de lentes que formaban un microscopio -
 En el año 1860 Luis Pasteur demostró el papel que tienen las bacterias en la fermentación de vinos y cervezas
En el año 1860 Luis Pasteur demostró el papel que tienen las bacterias en la fermentación de vinos y cervezas -
 En 1892 Franz Schardiger sugirió que la Escherichia coli seria útil como microorganismo indicador de la contaminación fecal
En 1892 Franz Schardiger sugirió que la Escherichia coli seria útil como microorganismo indicador de la contaminación fecal -
 En el año 1897 Kiyoshi Shiga identifico al agente causal de la disentería bacilar, la bacteria Shigella dysenteriae
En el año 1897 Kiyoshi Shiga identifico al agente causal de la disentería bacilar, la bacteria Shigella dysenteriae -
 En el año 1908, Charles Nicolle junto a Louis Manceaux aislaron, a partir del hígado y bazo de unos pequeños roedores africanos, un parásito intracelular al que denominaron Toxoplasma gondii
En el año 1908, Charles Nicolle junto a Louis Manceaux aislaron, a partir del hígado y bazo de unos pequeños roedores africanos, un parásito intracelular al que denominaron Toxoplasma gondii -
 En el año 1915, M.H. McCrady establece el enfoque cuantitativo para determinar el número más probable de coliformes en una muestra de agua contaminada
En el año 1915, M.H. McCrady establece el enfoque cuantitativo para determinar el número más probable de coliformes en una muestra de agua contaminada -
 En el año 1926, Everitt Murray aisló la bacteria Listeria monocytogenes, la cual puede crecer frecuentemente en la comida a temperaturas bajas y causar listeriosis en el hombre
En el año 1926, Everitt Murray aisló la bacteria Listeria monocytogenes, la cual puede crecer frecuentemente en la comida a temperaturas bajas y causar listeriosis en el hombre -
 En el año 1992. T. Cheasty et al. informaron de la nueva cepa de Vibrio cholerae, asociada con cólera epidémico.
En el año 1992. T. Cheasty et al. informaron de la nueva cepa de Vibrio cholerae, asociada con cólera epidémico. -
 En el año 2003 aparece la gripe aviar en Asia, producida por el subtipo HPAI A (H5NI) del virus Influenza A, que casualmente se puede transmitir al hombre
En el año 2003 aparece la gripe aviar en Asia, producida por el subtipo HPAI A (H5NI) del virus Influenza A, que casualmente se puede transmitir al hombre -
En el año 2007 se informa de la secuenciación del genoma de Saccharopolyspora erythraea, bacteria productora del antibiótico eritromicina.
En el año 2007 se informa de la secuenciación del genoma de Saccharopolyspora erythraea, bacteria productora del antibiótico eritromicina.
Want to make a timeline like this?
Use Timetoast to turn dates, events, milestones, and phases into a clear visual timeline you can build and share. Timetoast is a timeline maker for work, school, research, and stories.

